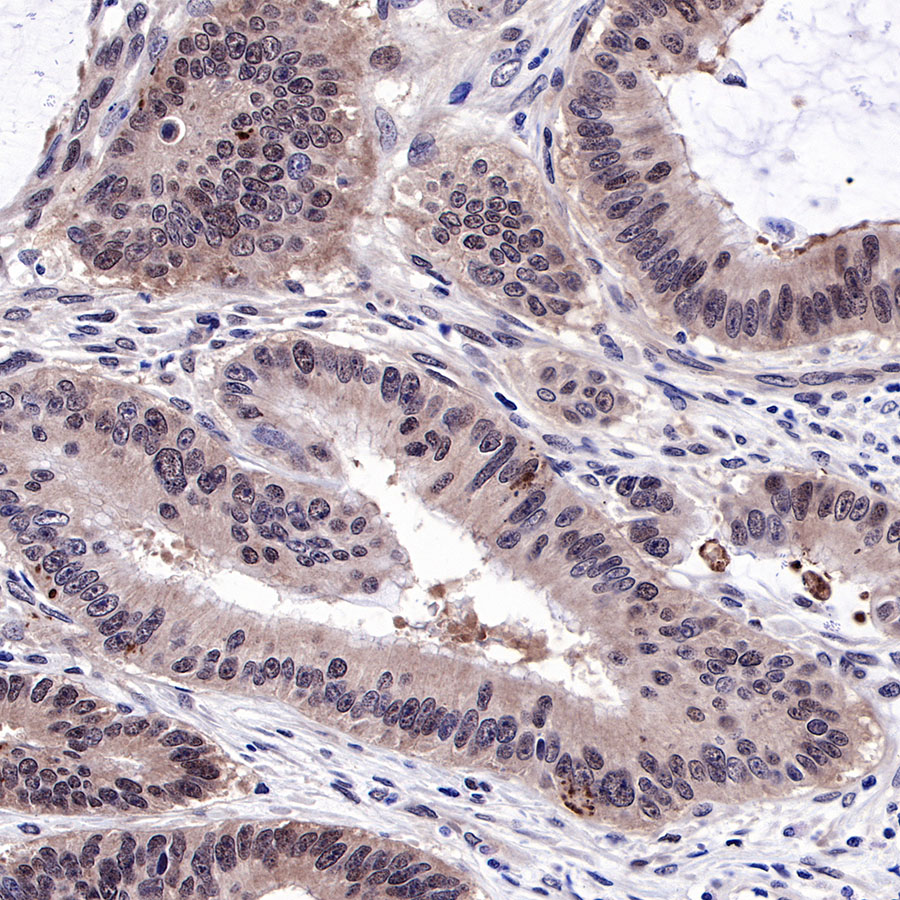

WB result of SMAD4 Rabbit mAb
Primary antibody: SMAD4 Rabbit mAb at 1/500 dilution
Lane 1: HT-29 whole cell lysate 20 µg
Lane 2: HepG2 whole cell lysate 20 µg
Lane 3: HCT 116 whole cell lysate 20 µg
Lane 4: Jurkat whole cell lysate 20 µg
Negative control: HT-29 whole cell lysate
Secondary antibody: Goat Anti-Rabbit IgG, (H+L), HRP conjugated at 1/10000 dilution
Predicted MW: 60 kDa
Observed MW: 65 kDa
Product Details
Product Details
Product Specification
Host | Rabbit |
Antigen | Smad4 |
Synonyms | Smad4, hSMAD4, DPC4 |
Immunogen | N/A |
Location | Cytoplasm, Nucleus |
Accession | Q13485 |
Clone Number | SDT-R114 |
Antibody Type | Rabbit mAb |
Application | WB, IHC-P |
Reactivity | Hu, Ms, Rt |
Purification | Protein A |
Concentration | 0.25 mg/ml |
Physical Appearance | Liquid |
Storage Buffer | PBS, 40% Glycerol, 0.05% BSA, 0.03% Proclin 300 |
Stability & Storage | 12 months from date of receipt / reconstitution, -20 °C as supplied |
Dilution
application | dilution | species |
WB | 1:500 | null |
IHC-P | 1:1000 | null |
Background
Picture
Picture
Western Blot


WB result of SMAD4 Rabbit mAb
Primary antibody: SMAD4 Rabbit mAb at 1/500 dilution
Lane 1: NIH/3T3 whole cell lysate 20 µg
Secondary antibody: Goat Anti-Rabbit IgG, (H+L), HRP conjugated at 1/10000 dilution
Predicted MW: 60 kDa
Observed MW: 65 kDa

WB result of SMAD4 Rabbit mAb
Primary antibody: SMAD4 Rabbit mAb at 1/500 dilution
Lane 1: C6 whole cell lysate 20 µg
Secondary antibody: Goat Anti-Rabbit IgG, (H+L), HRP conjugated at 1/10000 dilution
Predicted MW: 60 kDa
Observed MW: 65 kDa
Immunohistochemistry

IHC shows positive staining in paraffin-embedded human colon. Anti-SMAD4 antibody was used at 1/1000 dilution, followed by a HRP Polymer for Mouse & Rabbit IgG (ready to use). Counterstained with hematoxylin. Heat mediated antigen retrieval with Tris/EDTA buffer pH9.0 was performed before commencing with IHC staining protocol.
IHC shows positive staining in paraffin-embedded human colon cancer. Anti-SMAD4 antibody was used at 1/1000 dilution, followed by a HRP Polymer for Mouse & Rabbit IgG (ready to use). Counterstained with hematoxylin. Heat mediated antigen retrieval with Tris/EDTA buffer pH9.0 was performed before commencing with IHC staining protocol.

IHC shows partial loss of SMAD4 expression in paraffin-embedded human colon cancer. Anti-SMAD4 antibody was used at 1/1000 dilution, followed by a HRP Polymer for Mouse & Rabbit IgG (ready to use). Counterstained with hematoxylin. Heat mediated antigen retrieval with Tris/EDTA buffer pH9.0 was performed before commencing with IHC staining protocol.

IHC shows positive staining in paraffin-embedded human pancreatic cancer (Loss of SMAD4 expression in tumors but nuclear expression in stromal cells). Anti-SMAD4 antibody was used at 1/1000 dilution, followed by a HRP Polymer for Mouse & Rabbit IgG (ready to use). Counterstained with hematoxylin. Heat mediated antigen retrieval with Tris/EDTA buffer pH9.0 was performed before commencing with IHC staining protocol.

IHC shows positive staining in paraffin-embedded human breast cancer. Anti-SMAD4 antibody was used at 1/1000 dilution, followed by a HRP Polymer for Mouse & Rabbit IgG (ready to use). Counterstained with hematoxylin. Heat mediated antigen retrieval with Tris/EDTA buffer pH9.0 was performed before commencing with IHC staining protocol.

IHC shows positive staining in paraffin-embedded mouse cerebral cortex. Anti-SMAD4 antibody was used at 1/1000 dilution, followed by a HRP Polymer for Mouse & Rabbit IgG (ready to use). Counterstained with hematoxylin. Heat mediated antigen retrieval with Tris/EDTA buffer pH9.0 was performed before commencing with IHC staining protocol.








